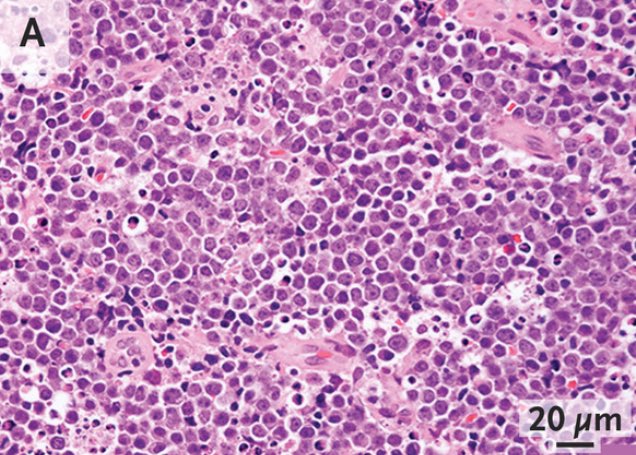
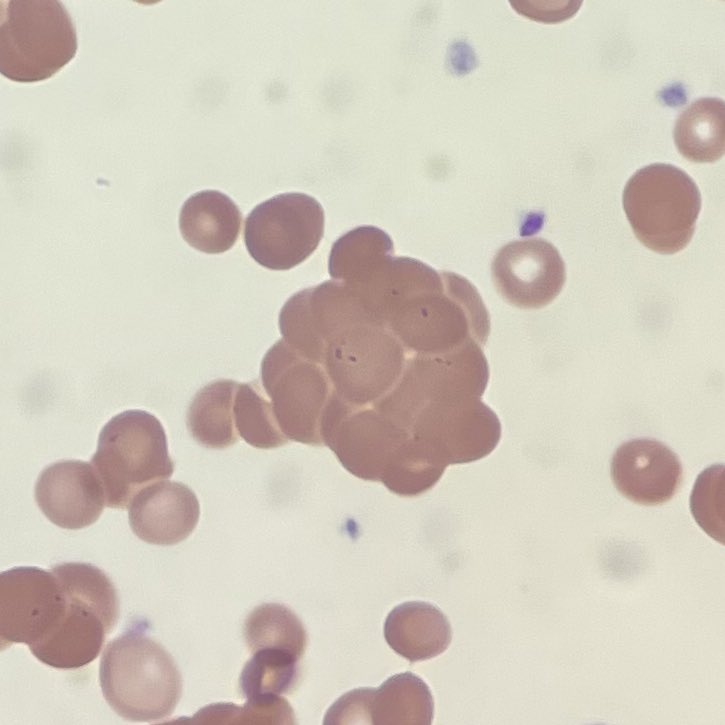

Picture this:
A patient presents with palpitations, and you find this 👇 on your evaluation.
Why (and how) is this an emergency? 🤔
A #tweetorial 🧵 1/7

A patient presents with palpitations, and you find this 👇 on your evaluation.
Why (and how) is this an emergency? 🤔
A #tweetorial 🧵 1/7


To guide our thoughts, here are 2 tumor lysis syndrome (TLS) facts-
1) 🔑 Electrolyte balance across a membrane drives action potential
2) When cells die, they release electrolytes (& nucleic acids) from intra ➡️ extracellular space
🧵 2/7
1) 🔑 Electrolyte balance across a membrane drives action potential
2) When cells die, they release electrolytes (& nucleic acids) from intra ➡️ extracellular space
🧵 2/7

The lab criteria above 👆 was created with treatment-related TLS in mind…
but spontaneous TLS can actually have HYPOphosphatemia 🤔
Why can phosphorous be ⬇️ in spontaneous TLS?
🧵 3/7
but spontaneous TLS can actually have HYPOphosphatemia 🤔
Why can phosphorous be ⬇️ in spontaneous TLS?
🧵 3/7
Treatment-related TLS is due to cell death (☠️), compared to…
🔑 spontaneous TLS which is due to ⬆️ cell turnover (👶🏻 & ☠️)
Leukemic blasts (👶🏻) have ~4x normal phosphorous demands which ⬇️ supply 🤯
🧵 4/7
🔑 spontaneous TLS which is due to ⬆️ cell turnover (👶🏻 & ☠️)
Leukemic blasts (👶🏻) have ~4x normal phosphorous demands which ⬇️ supply 🤯
🧵 4/7

Let’s break down TLS treatment into 2 parts-
1️⃣ Electrolyte management (HyperK and hypoCa/hypoPhos)
2️⃣ Uric acid management (fluids, allopurinol, +/- rasburicase)
🧵 5/7
1️⃣ Electrolyte management (HyperK and hypoCa/hypoPhos)
2️⃣ Uric acid management (fluids, allopurinol, +/- rasburicase)
🧵 5/7
🤔 When should we use rasburicase?
🔑 Conservative rasburicase use is non-inferior to aggressive use
In this study👇 rasburicase was only *considered* for those with:
- high risk features
- AND uric acid > 9 mg/dL
🧵 6/7
🔑 Conservative rasburicase use is non-inferior to aggressive use
In this study👇 rasburicase was only *considered* for those with:
- high risk features
- AND uric acid > 9 mg/dL
🧵 6/7

Key takeaways:
🔑 TLS is a syndrome of electrolyte abnormalities and kidney injury from ⬆️ cell lysis
🚩 Watch out for ⬇️ phos in STLS!
🔑 Use rasburicase conservatively
… and food for thought:
🤔 As therapies improve, will ⬆️ oncolytic effect lead to more TLS?
🧵 7/end
🔑 TLS is a syndrome of electrolyte abnormalities and kidney injury from ⬆️ cell lysis
🚩 Watch out for ⬇️ phos in STLS!
🔑 Use rasburicase conservatively
… and food for thought:
🤔 As therapies improve, will ⬆️ oncolytic effect lead to more TLS?
🧵 7/end
Thanks for sticking around- I hope we all learned something new!
Thank you to @OllilaTom for peer review 👏
For a deeper dive, here are the full articles:
pubmed.ncbi.nlm.nih.gov/23211092/
pubmed.ncbi.nlm.nih.gov/28077046/
and images:
ahajournals.org/doi/10.1161/ci…
imagebank.hematology.org/image/2201/ph-…
Thank you to @OllilaTom for peer review 👏
For a deeper dive, here are the full articles:
pubmed.ncbi.nlm.nih.gov/23211092/
pubmed.ncbi.nlm.nih.gov/28077046/
and images:
ahajournals.org/doi/10.1161/ci…
imagebank.hematology.org/image/2201/ph-…
Thank you to @Berninini and @ajperissinotti for the excellent study above 👏
Looking forward to hearing what others would add!
@dhughesPharmD @lynnettehenshaw @JPatel_PharmD @JessicaFRx1 @ManniMD1 @tony_breu @HemeOncPharm @OncBrothers @amarkelkar @DxRxEdu @rabihmgeha
Looking forward to hearing what others would add!
@dhughesPharmD @lynnettehenshaw @JPatel_PharmD @JessicaFRx1 @ManniMD1 @tony_breu @HemeOncPharm @OncBrothers @amarkelkar @DxRxEdu @rabihmgeha
• • •
Missing some Tweet in this thread? You can try to
force a refresh